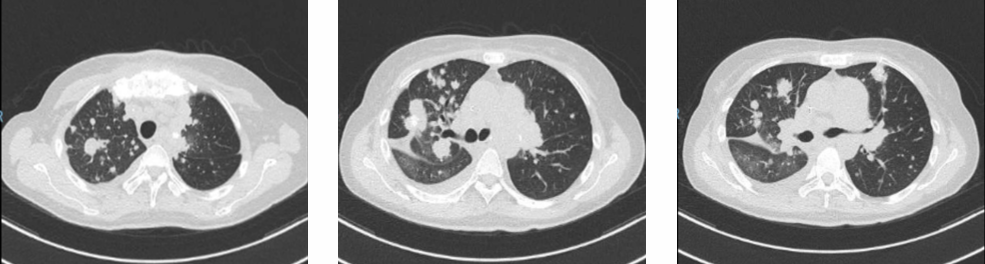

查看更多
密码过期或已经不安全,请修改密码
修改密码
壹生身份认证协议书
同意
拒绝
同意
拒绝
同意
不同意并跳过
基本资料
性别:女
年龄:48岁
主诉:因“结肠癌术后7年余,间断咳嗽咳痰一月余”于 2017.1.4 就诊
现病史:患者于2009年在外院行左半结肠癌根治术并行术后辅助治疗(具体不详)。2016年11月开始间断咳嗽且进行性加重,伴有咳白色黏痰
既往史:无特殊病史
辅助检查
查体:
ECOG 1分,心肺腹(-)
实验室检查:
血常规及生化:未见异常
肿瘤标志物:
CEA:175.9ug/L ↑↑
CA199:59.9U/ml ↑
CA125:12.8U/ml
影像学检查:
2016.12外院肺部CT:双肺多发肿块影并钙化,纵膈淋巴结肿大并钙化

外院腹盆腔CT:结肠脾区附近脂肪间隙略浑浊,结合病史考虑为术后改变。
肺结节穿刺病理:
病理诊断:
(右肺穿刺活检)转移性腺癌,根据病史及免疫组化标记,符合肠癌中分化转移性腺癌
基因检测:KRAS/NRAS/BRAF野生型 pMMR
诊断:
左半结肠腺癌根治术后进展(肺多发)
KRAS/NRAS/BRAF野生型 pMMR
制定治疗目标:
PS 1分
合并双肺多发转移,不可切除
治疗目标:
延长生存时间
改善生活质量
女性,对生活质量要求高
金融人员
治疗过程:
晚期一线治疗:
2017年1月 行FOLFIRI + 西妥昔单抗 方案治疗1周期 (严重皮疹)
2017年2月~9月 行FOLFIRI + 贝伐单抗 方案治疗11周期
疗效:PR,患者要求终止治疗,进入随访
CEA :175.9ug/L → 18.56ug/L
CA199 下降至正常
12周期后疗效评价为PR
2017年11月 分别对右上肺及左上肺病灶放疗 PTV 50GY/5F
一线治疗影像评估:
2017年1月


2017年9月


一线治疗疗效评价:
肿瘤标志物进行性下降

一线治疗后疾病进展:
2018年4月:左下肢疼痛麻木,不能行走再次就诊
ECOG 1分,心肺腹(-)
血常规及生化:未见异常
肿瘤标志物:
CEA:467.85ug/L ↑↑
CA199:71.2U/ml ↑
CA125:13.9U/ml
影像学检查:
2018.04

晚期二线治疗:
止痛治疗:NRS 8分,吗啡、非甾体药止痛
2018.4 放疗:髂骨转移瘤姑息放疗 36GY/12F
2018.4---2019.4 全身治疗:
替吉奥(50mg bid d1-14 Q3W)+
瑞戈非尼(160mg qd d1-21 Q4W)
2018.8.21 胸骨转移瘤放疗 35GY/5F
二线治疗PFS: 12m
二线治疗后影像评估:
瑞戈非尼前,2018.04

瑞戈非尼中,2018.07

瑞戈非尼前,2018.04

瑞戈非尼中,2018.07

瑞戈非尼前,2018.04

瑞戈非尼中,2018.07

二线治疗疗效评估:
肿瘤标志物进行性下降

二线治疗不良反应:
PS 1分
疼痛明显减轻,NRS 8分 2分,基本不用止痛药物
生活质量较高,可行走,体重增加
手足皮肤反应、高血压、肝损伤、蛋白尿:未见
声音稍嘶哑
影像评估:
2017年9月

2018年4月

2018年7月

2019年4月

2017年9月

2018年4月

2018年7月

2019年4月

2017年9月

2018年4月

2018年7月

2019年4月

2017年9月

2018年4月

2018年7月

2019年4月

2018年4月

2018年7月

2019年1月

2019年4月

晚期三线治疗:
2019.4复查影像学:转移灶再次进展
2019.4.17-2019.5.28 单药伊立替康 3周期
不良反应:III度胃肠道反应,I度骨髓抑制
三线治疗后疗效评价:
2019年4月

2019年6月
四线治疗:
2019.6.24-2019.9.6 行 希罗达+安维汀 3周期
不良反应:耐受可,未见明显的不良反应
四线治疗后疗效评价:
2019年6月

2019年9月

五线治疗:
2019.9.27、2019.10.18 行 瑞格菲尼+信迪利单抗 2周期
手足皮肤反应、高血压、肝损伤、蛋白尿:未见
病例总结:
查看更多